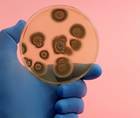
ReachMD Healthcare Image

advertisement
News
See the Latest in Oncology News
1217-1232 of 1299
medicalxpress.com
01/22/2024
medicalxpress.com
01/22/2024
reuters.com
01/22/2024
today.ucsd.edu
01/19/2024
manchester.ac.uk
01/19/2024
health.ucdavis.edu
01/19/2024
forbes.com
01/18/2024
medicalxpress.com
01/18/2024- Medical NewsStudy Finds No Increase in Preventable Illnesses, Deaths in Kids During Pandemic, But Delays in Some Diagnoses
medicalxpress.com
01/18/2024
health.ucsd.edu
01/18/2024
news.weill.cornell.edu
01/18/2024- Medical NewsIncreased Body and Abdominal Fat in Teenagers Can Lead to ‘Vicious Cycle’ Ending in Type 2 Diabetes
news.exeter.ac.uk
01/18/2024
medicalxpress.com
01/18/2024- Medical NewsSamsung Electronics Co., Ltd., (Suwon, Republic of Korea) Developed Hip-Assist Robot to Advance Fitness in the Elderly
bioengineer.org
01/18/2024 - Medical NewsUniversity of North Carolina Study Finds Infliximab Biosimilars Comparable to Remicade in Gastroenterology and Rheumatology Clinics
managedhealthcareexecutive.com
01/17/2024 - Medical NewsRechargeable Deep Brain Stimulation Device Receives Approval from FDA as Treatment for Movement Disorders and Epilepsy
practicalneurology.com
01/17/2024